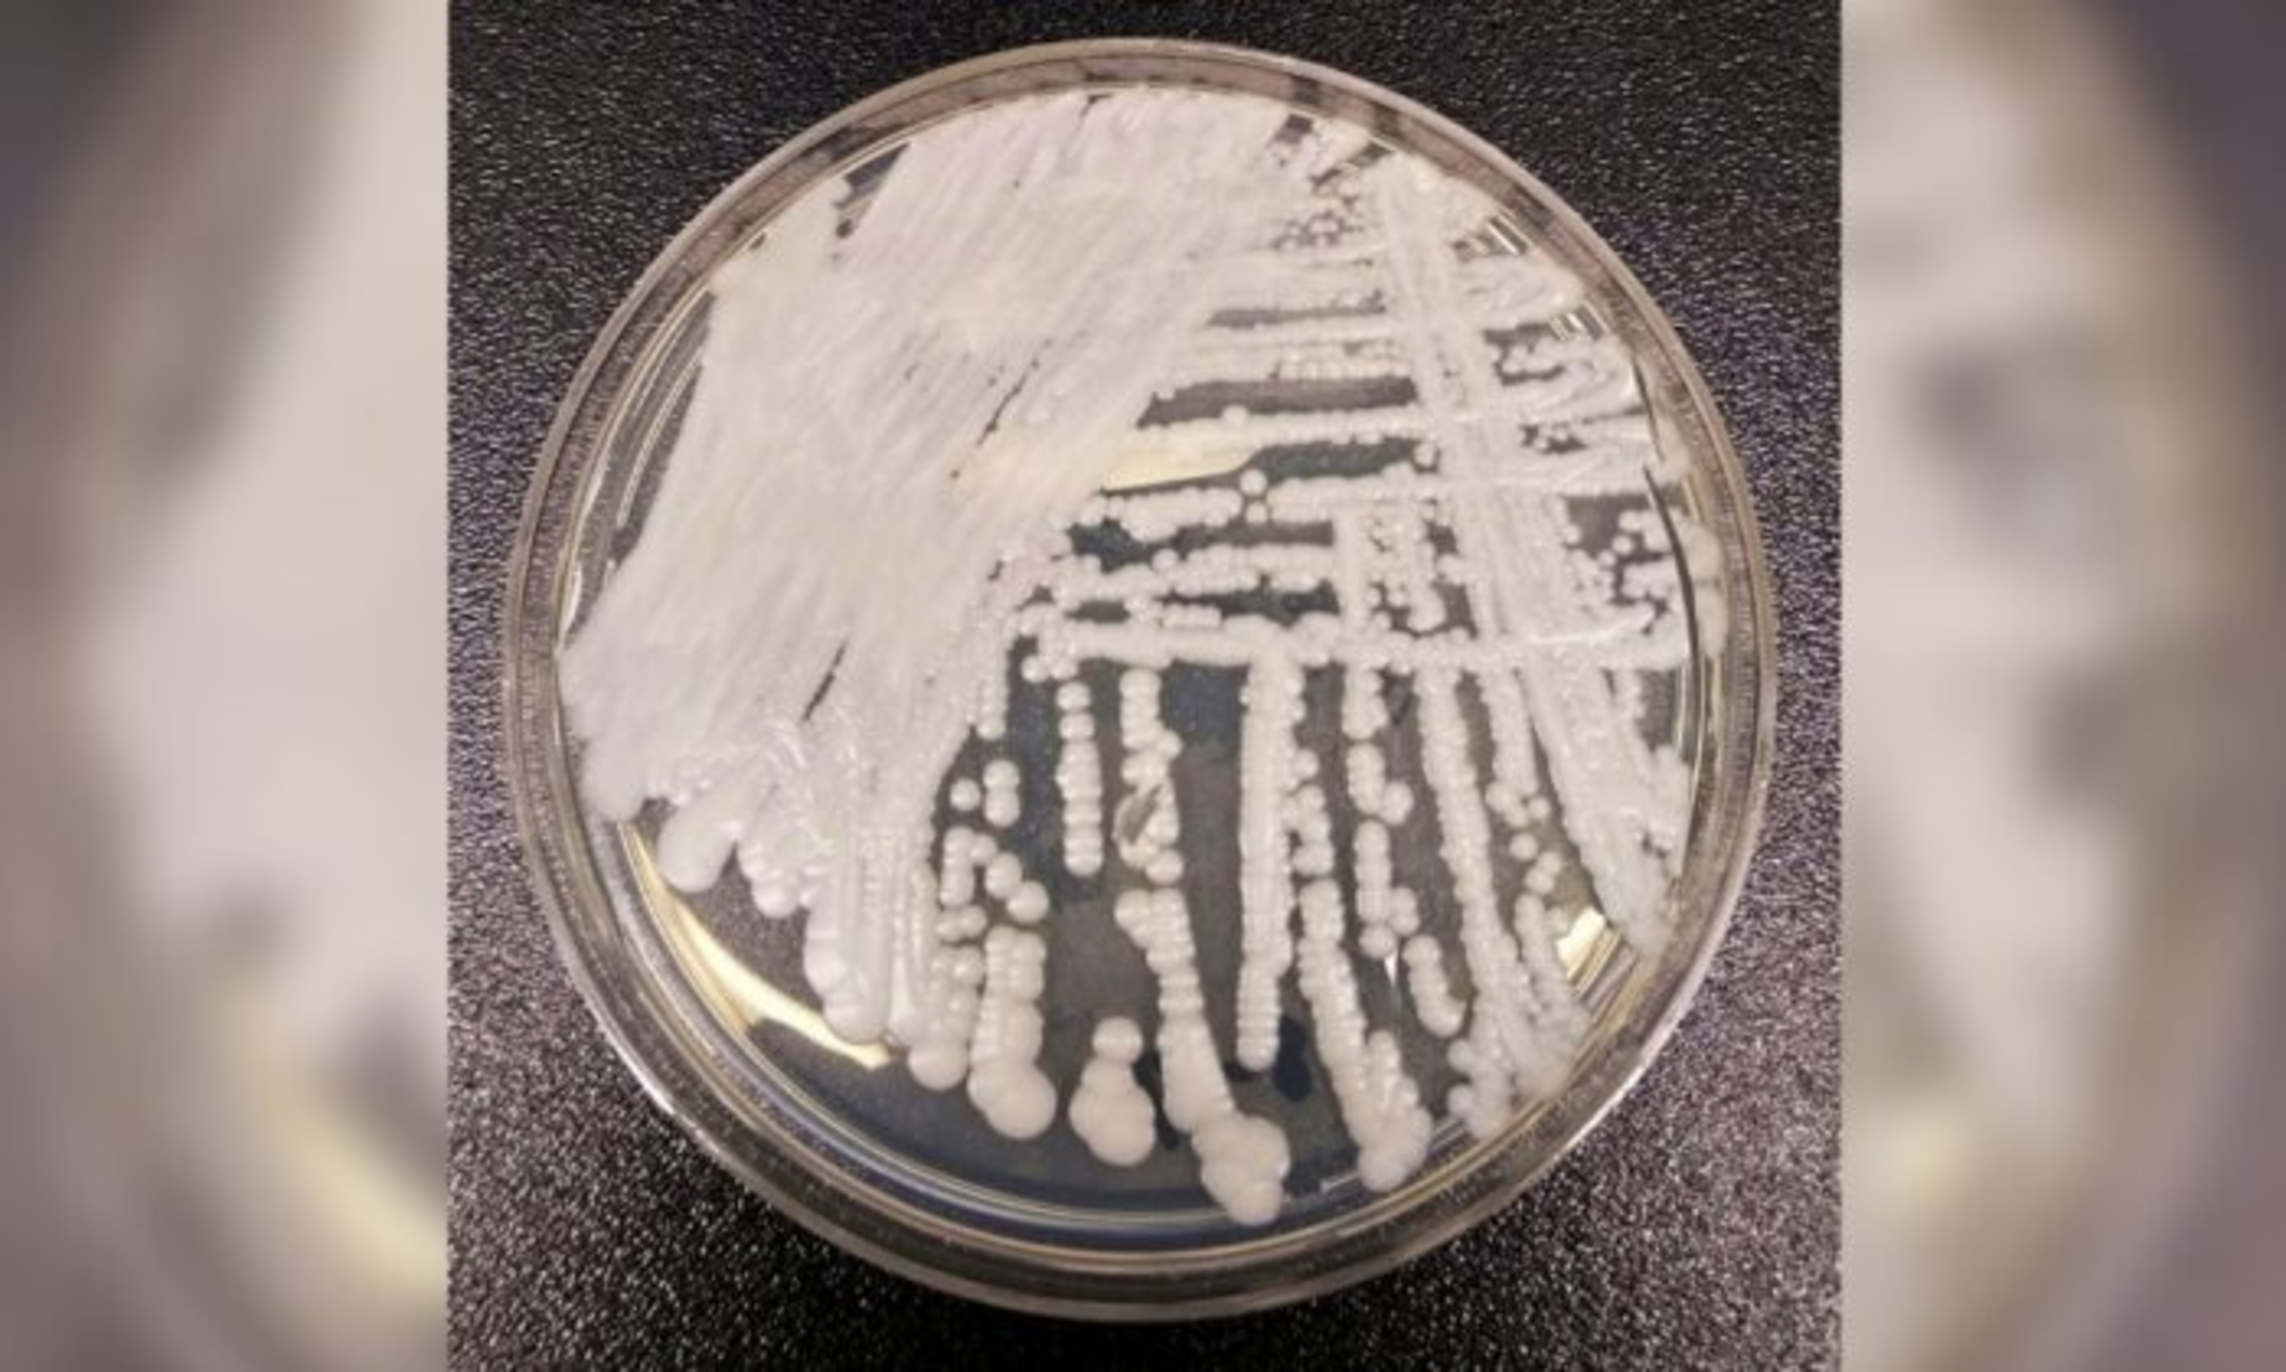

First Outbreak of Deadly Fungal Infection Confirmed in Washington State, Officials Say
Published on February 1, 2024
Authorities in Washington state confirmed an outbreak of a deadly fungal infection that has been on the rise across the United States in recent years. Officials in King County, Washington, said in a statement on Tuesday that an outbreak involving three patients infected by Candida auris, or C. auris, was reported at Kindred Hospital in Seattle beginning in mid-January. Another case was detected on Jan. 26 at a nursing home in nearby Snohomish County, officials said. “These patients had previously tested negative for C. auris when they were first admitted,” it said. “This is the first known outbreak of C. auris in Washington state.”...
